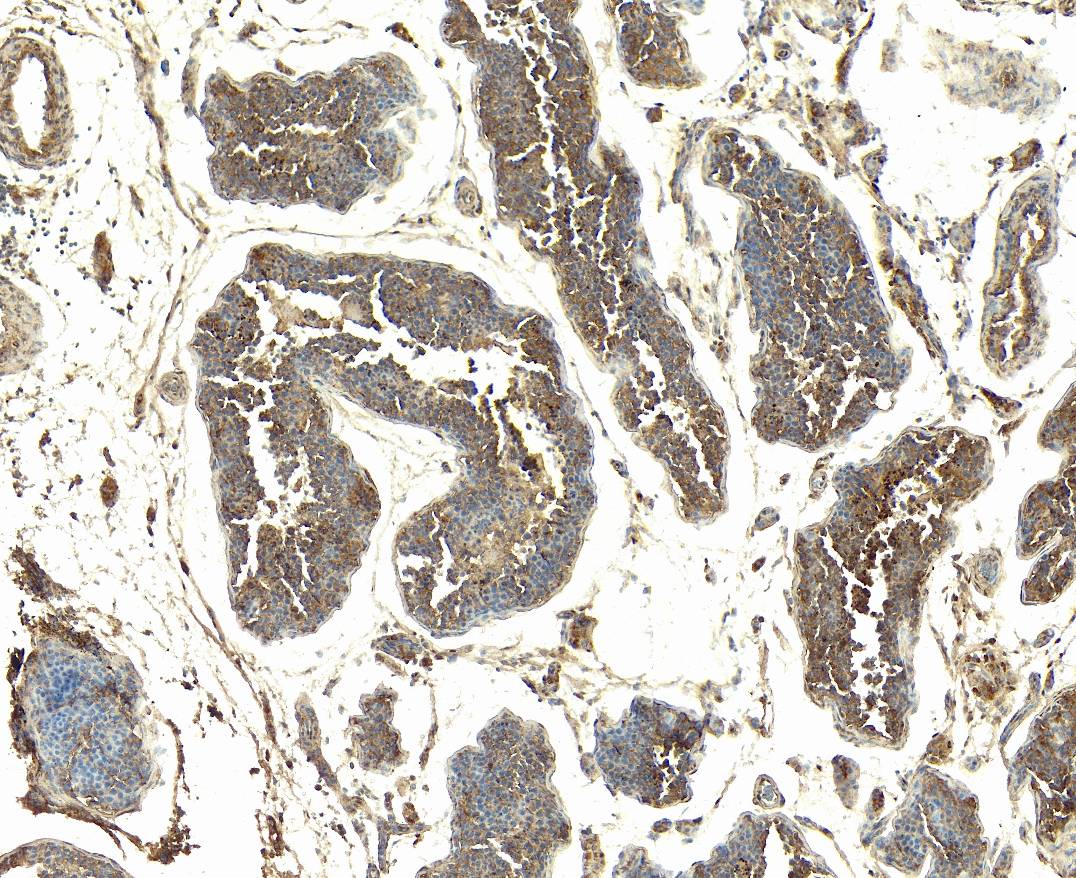

Macrophages (M1 + M2 Markers)
Macrophages are a highly diverse cell population, exhibiting phenotypic heterogeneity and functional specialization, and play crucial roles in both innate and adaptive immunity. There are two main subtypes: M1 (classically activated, exhibiting a pro-inflammatory phenotype and are necessary for pathogenic defence) and M2 (alternatively activated, exhibiting an anti-inflammatory phenotype, involved in the resolution of inflammation and tissue repair).
Please view our M1 + M2 Marker antibodies below and find the flyer here:
![]() | ![]() | ![]() |
| EB11331 Flow cytometric analysis of paraformaldehyde fixed A431 cells (blue line), permeabilized with 0.5% Triton. | EB06772 (4µg/ml) staining of paraffin embedded Human Testis. Heat induced antigen retrieval with citrate buffer pH 6, HRP-staining. | EB10107 Immunofluorescence analysis of paraformaldehyde fixed A549 cells, permeabilized with 0.15% Triton. |
Antibodies for Macrophages (M1 + M2 Markers)
| Everest code | Principal name | Applications Tested | Species reactivity | Size available |
|---|---|---|---|---|
| EB07691 | Goat Anti-AKT1 Antibody | Pep-ELISA, WB, IF, FC | Human, Mouse | 100µg/200µl |
| EB06875 | Goat Anti-AKT1 Antibody | Pep-ELISA, WB | Human, Mouse, Cow | 100µg/200µl |
| EB06772 | Goat Anti-AKT2 Antibody | Pep-ELISA, WB, IHC | Human, Mouse, Rat, Dog | 100µg/200µl |
| EB07159 | Goat Anti-AKT2 Antibody | Pep-ELISA, IF, FC | Human, Mouse, Rat | 100µg/200µl |
| EB06562 | Goat Anti-AKT3 Antibody | Pep-ELISA, WB, IHC, IF, FC | Human, Mouse, Rat, Dog, Cow | 100µg/200µl |
| EB06795 | Goat Anti-Arginase I Antibody | Pep-ELISA, WB, IF, IHC | Human, Dog, Cow, Pig | 100µg/200µl |
| EB07706 | Goat Anti-Arginase, type 1 / ARG1 Antibody | Pep-ELISA, WB, IHC, IF | Human, Dog | 100µg/200µl |
| EB07707 | Goat Anti-Arginase, type 1 / arg1(rat) Antibody | Pep-ELISA, WB, IF | Mouse, Rat | 100µg/200µl |
| EB09667 | Goat Anti-CCL20 Antibody | Pep-ELISA, IHC | Human, Cow, Pig | 100µg/200µl |
| EB09000 | Goat Anti-CCL3L1 Antibody | Pep-ELISA | Human | 100µg/200µl |
| EB07239 | Goat Anti-CCR2 Antibody | Pep-ELISA, IF, IHC, FC | Human | 100µg/200µl |
| EB12341 | Goat Anti-CD163 (aa871-882) Antibody | Pep-ELISA, WB, IHC | Human | 100µg/200µl |
| EB12340 | Goat Anti-CD163 Antibody | Pep-ELISA, WB, IHC, FC | Human | 100µg/200µl |
| EB06621 | Goat Anti-CD274 / PD-L1 Antibody | Pep-ELISA, WB, IF, FC | Human | 100µg/200µl |
| EB12699 | Goat Anti-CD68 Antibody | Pep-ELISA, WB, IHC, FC | Human | 100µg/200µl |
| EB09701 | Goat Anti-CD80 Antibody | Pep-ELISA, WB, IHC, FC | Human | 100µg/200µl |
| EB10738 | Goat Anti-CD86 / B7-2 (aa273-286) Antibody | Pep-ELISA | Human | 100µg/200µl |
| EB10739 | Goat Anti-CD86 / B7-2 (aa 73-87) Antibody | Pep-ELISA, IHC | Human | 100µg/200µl |
| EB10257 | Goat Anti-CSF1R (aa 700-710) Antibody | Pep-ELISA, WB-Trf | Human, Mouse, Rat, Dog, Cow | 100µg/200µl |
| EB10258 | Goat Anti-CSF1R (aa734-744) Antibody | Pep-ELISA, FC, IHC, WB | Human, Dog, Cow | 100µg/200µl |
| EB12715 | Goat Anti-DC-SIGN / CD209 Antibody | Pep-ELISA, WB, IHC, IF, FC | Human | 100µg/200µl |
| EB12555 | Goat Anti-FCGR1A/CD64 Antibody | Pep-ELISA, WB, FC | Human | 100µg/200µl |
| EB12342 | Goat Anti-IL-1 beta Antibody | Pep-ELISA, WB | Human | 100µg/200µl |
| EB10107 | Goat Anti-IL1R2 Antibody | Pep-ELISA, WB, IF, FC | Human | 100µg/200µl |
| EB11755 | Goat Anti-IL-6 (aa138-148) Antibody | Pep-ELISA, IF, IHC | Human | 100µg/200µl |
| EB11331 | Goat Anti-IRF4 (aa393-407) Antibody | Pep-ELISA, WB, IHC, FC | Human, Mouse, Rat, Dog, Cow | 100µg/200µl |
| EB11330 | Goat Anti-IRF4 Antibody | Pep-ELISA, WB | Human | 100µg/200µl |
| EB07825 | Goat Anti-ITGAM / CD11B Antibody | Pep-ELISA, IF, IHC | Human | 100µg/200µl |
| EB07241 | Goat Anti-PPARG Antibody | Pep-ELISA, IF | Human, Mouse, Rat | 100µg/200µl |
| EB11961 | Goat Anti-RANTES Antibody | Pep-ELISA, IHC | Human | 100µg/200µl |
| EB05040 | Goat Anti-SOCS1 Antibody | Pep-ELISA, FC, IF, IHC | Human, Mouse, Dog, Cow, Rat, Pig | 100µg/200µl |
| EB05104 | Goat Anti-SOCS2 Antibody | Pep-ELISA, IHC | Human, Mouse, Rat | 100µg/200µl |
| EB07852 | Goat Anti-TGM2 Antibody | Pep-ELISA, FC, WB | Human, Dog, Cow | 100µg/200µl |
| EB07827 | Goat Anti-TGM2 Antibody | Pep-ELISA, WB, IHC, FC | Human | 100µg/200µl |
| EB11080 | Goat Anti-Transglutaminase 2 (aa17-29) Antibody | Pep-ELISA, IF | Human, Mouse, Rat, Pig, Cow | 100µg/200µl |
| EB11081 | Goat Anti-Transglutaminase 2 (aa578-591) Antibody | Pep-ELISA, WB | Human, Mouse, Rat, Pig, Cow | 100µg/200µl |